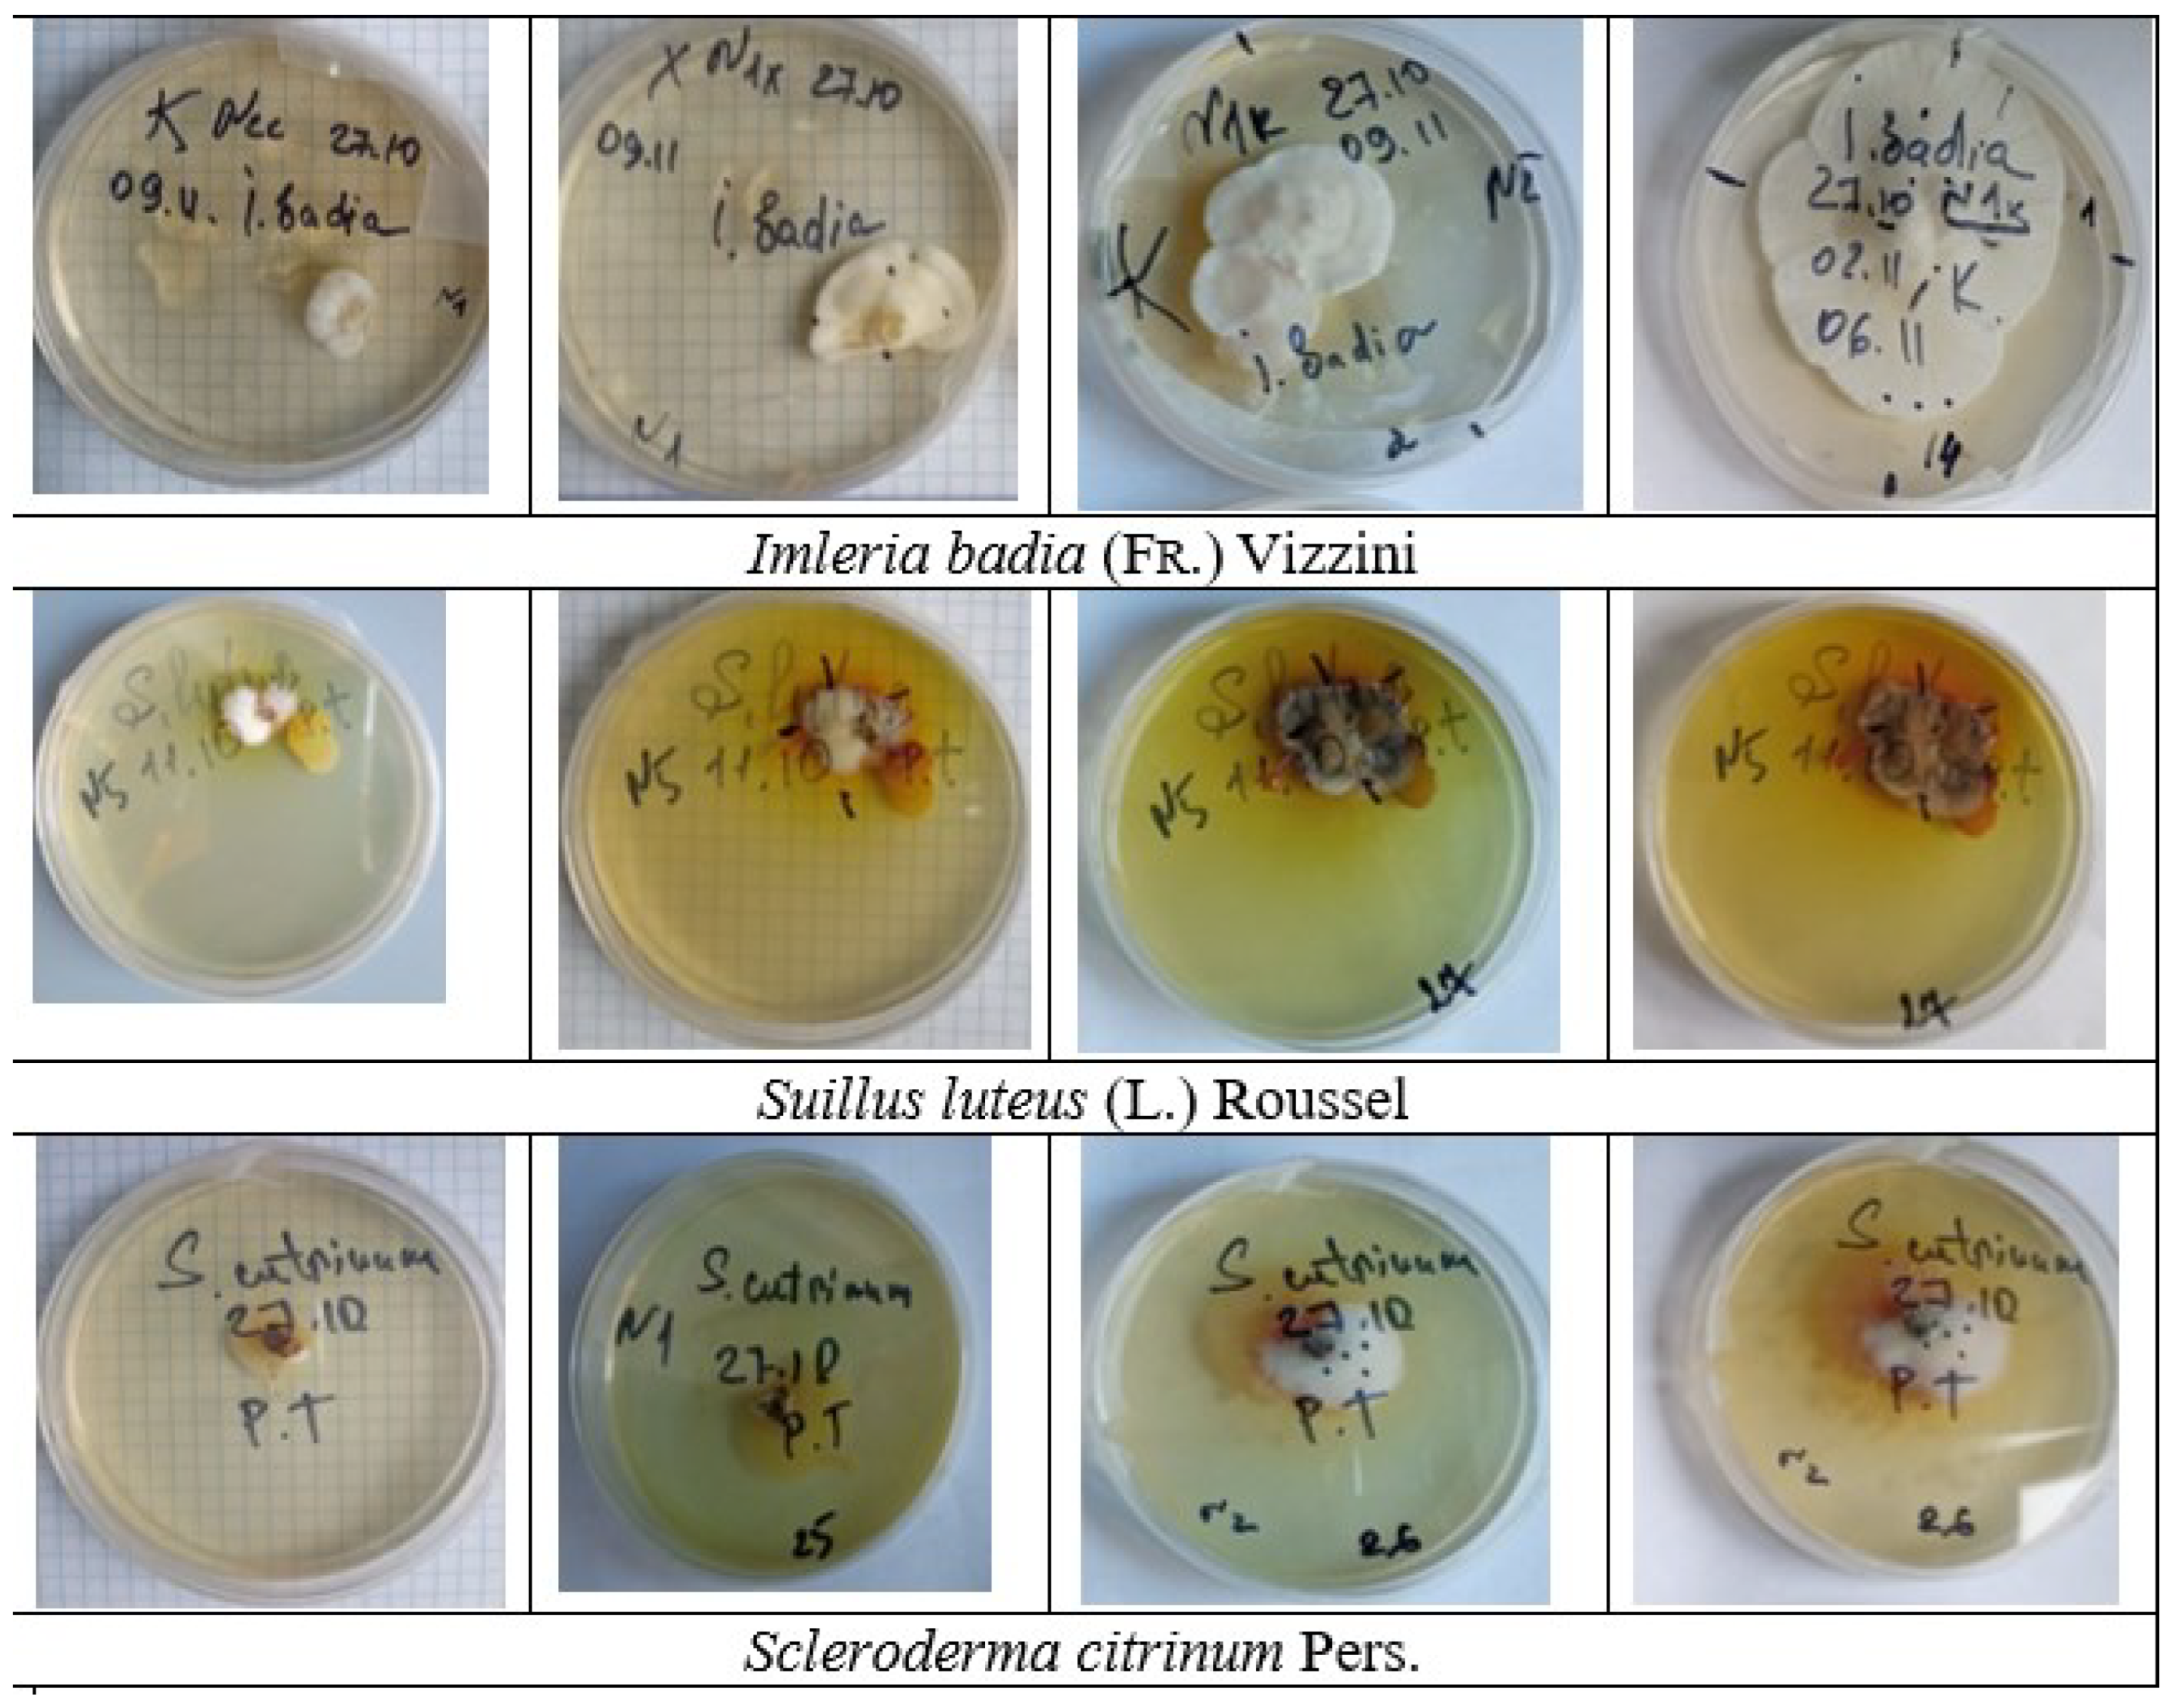
Plants 13 00506 g001

An Overview of Mycorrhiza in Pines: Research, Species, and Applications
Abstract
1. Introduction
2. Invaluable Mycorrhizal Network
3. Mycorrhizal Components of Pine Trees and Their Properties
4. Peculiarities of Ectomycorrhizal Fungi and Their Characteristics
5. Cultivation of Pure Cultures
6. Peculiarities of the Mycorrhizal Structure and Its Influence on the Growth and Development of Pinus Species
7. Effects of Climate Change on Mycorrhizal Fungi
8. Role of Mycorrhiza in the Control of Pathogens
9. Conclusions
Author Contributions
Funding
Institutional Review Board Statement
Informed Consent Statement
Data Availability Statement
Conflicts of Interest
References
- Dyderski, M.K.; Paź, S.; Frelich, L.E.; Jagodziński, A.M. How much does climate change threaten European forest tree species distributions? Glob. Chang. Biol. 2018, 24, 1150–1163. [Google Scholar] [CrossRef]
- Brichta, J.; Šimůnek, V.; Bílek, L.; Vacek, Z.; Gallo, J.; Drozdowski, S.; Bravo-Fernández, J.A.; Mason, B.; Roig Gomez, S.; Hájek, V.; et al. Effects of Climate Change on Scots Pine (Pinus sylvestris L.) Growth across Europe: Decrease of Tree-Ring Fluctuation and Amplification of Climate Stress. Forests 2024, 15, 91. [Google Scholar] [CrossRef]
- Finlay, R.; Read, D. The structure and function of the vegetative mycelium of ectomycorrhizal plants: II. The uptake and distribution of phosphorus by mycelial strands interconnecting host plants. New Phytol. 1986, 103, 157–165. [Google Scholar] [CrossRef]
- Finlay, R.; Ek, H.; Odham, G.; Söderström, B. Mycelial uptake, translocation and assimilation of nitrogen from 15N-labelled ammonium by Pinus sylvestris plants infected with four different ectomycorrhizal fungi. New Phytol. 1988, 110, 59–66. [Google Scholar] [CrossRef]
- Smith, S.E.; Read, D.J. Mycorrhizal Symbiosis; Academic Press: Cambridge, MA, USA, 2010. [Google Scholar]
- van Der Heijden, M.G.; Martin, F.M.; Selosse, M.A.; Sanders, I.R. Mycorrhizal ecology and evolution: The past, the present, and the future. New Phytol. 2015, 205, 1406–1423. [Google Scholar] [CrossRef]
- Tedersoo, L.; Bahram, M.; Zobel, M. How mycorrhizal associations drive plant population and community biology. Science 2020, 367, eaba1223. [Google Scholar] [CrossRef] [PubMed]
- Simard, S.W.; Beiler, K.J.; Bingham, M.A.; Deslippe, J.R.; Philip, L.J.; Teste, F.P. Mycorrhizal networks: Mechanisms, ecology and modelling. Fungal Biol. Rev. 2012, 26, 39–60. [Google Scholar] [CrossRef]
- Neuenkamp, L.; Moora, M.; Öpik, M.; Davison, J.; Gerz, M.; Männistö, M.; Jairus, T.; Vasar, M.; Zobel, M. The role of plant mycorrhizal type and status in modulating the relationship between plant and arbuscular mycorrhizal fungal communities. New Phytol. 2018, 220, 1236–1247. [Google Scholar] [CrossRef]
- Malewski, T.; Borowik, P.; Olejarski, I.; Berezovska, D.; Dyshko, V.; Behnke-Borowczyk, J.; Pusz, W.; Matic, S.; Oszako, T. Mycobiome of Post-Agricultural Soils 20 Years after Application of Organic Substrates and Planting of Pine Seedlings. Forests 2022, 14, 36. [Google Scholar] [CrossRef]
- Malewski, T.; Borowik, P.; Olejarski, I.; Rutkiewicz, A.; Okorski, A.; Oszako, T. Addition of Organic Matter to Pine Plantations on Agricultural Land Positively Alters the Mycobiome of Agricultural Soils. Appl. Sci. 2023, 13, 5800. [Google Scholar] [CrossRef]
- Van Der Heijden, M.G.; Bardgett, R.D.; Van Straalen, N.M. The unseen majority: Soil microbes as drivers of plant diversity and productivity in terrestrial ecosystems. Ecol. Lett. 2008, 11, 296–310. [Google Scholar] [CrossRef]
- Bever, J.D.; Dickie, I.A.; Facelli, E.; Facelli, J.M.; Klironomos, J.; Moora, M.; Rillig, M.C.; Stock, W.D.; Tibbett, M.; Zobel, M. Rooting theories of plant community ecology in microbial interactions. Trends Ecol. Evol. 2010, 25, 468–478. [Google Scholar] [CrossRef]
- Mao, Z.; Corrales, A.; Zhu, K.; Yuan, Z.; Lin, F.; Ye, J.; Hao, Z.; Wang, X. Tree mycorrhizal associations mediate soil fertility effects on forest community structure in a temperate forest. New Phytol. 2019, 223, 475–486. [Google Scholar] [CrossRef] [PubMed]
- Vogt, K. Mycorrhizal role in net primary production and nutrient cycling in Abies amabilis ecosystems in western Washington. Ecology 1982, 63, 370–380. [Google Scholar] [CrossRef]
- Nylund, J.E.; Wallander, H. Effects of ectomycorrhiza on host growth and carbon balance in a semi-hydroponic cultivation system. New Phytol. 1989, 112, 389–398. [Google Scholar] [CrossRef]
- Brunner, I.; Amiet, R.; Zollinger, M.; Egli, S. Ectomycorrhizal syntheses with Picea abies and three fungal species: A case study on the use of an in vitro technique to identify naturally occurring ectomycorrhizae. Mycorrhiza 1992, 2, 89–96. [Google Scholar] [CrossRef]
- Rudawska, M. Rola ektomikoryz w biologicznej ochronie drzew lesnych przed patogenami glebowymi. Sylwan 2000, 144, 27–39. [Google Scholar]
- Hilszczanska, D. Mikoryzy i ich rola w środowisku. Sylwan 1997, 141, 59–64. [Google Scholar]
- Hilszczańska, D. Mycorrhizal fungi in Scots pine cultures after seedlings out planting on post-agricultural lands. Folia For. Pol. Ser. A-For. 2002, 44, 97–102. [Google Scholar]
- Bzdyk, R.M.; Olchowik, J.; Studnicki, M.; Oszako, T.; Sikora, K.; Szmidla, H.; Hilszczańska, D. The impact of effective microorganisms (EM) and organic and mineral fertilizers on the growth and mycorrhizal colonization of Fagus sylvatica and Quercus robur seedlings in a bare-root nursery experiment. Forests 2018, 9, 597. [Google Scholar] [CrossRef]
- Davydenko, K.; Vysotska, N.; Yushchyk, V.; Markina, T. Early effects of a forest fire on the diversity of fungal communities in pine forests in Left-Bank Ukraine with special emphasis on mycorrhizal fungi. For. For. Melior. 2020, 9, 110–119. [Google Scholar] [CrossRef]
- Kuznetsova, O.; Vlasenko, E. Effect of natural and synthetic phytohormones on growth and development of higher Basidiomycetes. Biotechnol. Acta 2020, 13, 19–31. [Google Scholar] [CrossRef]
- Kopia, L.; Gonchar, V.; Kopia, S.; Oliferchuk, V.; Kopia, M. Influence of tree stand composition on the mycological structure of the soil. Sci. Bull. Nltu Ukr. 2015, 25, 8–14. [Google Scholar]
- Pachlewski, R.; Pachlewska, J. Studies on Symbiotic Properties of Mycorrhizal Fungi of Pine (Pinus silvestris L.) with the Aid of the Method of Mycorrhizal Synthesis in Pure Cultures on Agar; Forest Research Institute: Warsaw, Poland, 1974; p. 228. [Google Scholar]
- Malewski, T.; Borowik, P.; Golińska, P.; Okorski, A.; Olejarski, I.; Oszako, T. Organic Inputs Positively Alter the Bacteriome of Post-Agricultural Soils. Forests 2023, 14, 1711. [Google Scholar] [CrossRef]
- Society, B.M. Transactions of the British Mycological Society; Cambridge University Press: Cambridge, UK, 1924. [Google Scholar]
- Trappe, J.M. Fungus associates of ectotrophic mycorrhizae. Bot. Rev. 1962, 28, 538–606. [Google Scholar] [CrossRef]
- Ugarov, V.; Popov, O.; Danylenko, O.; Nozhenko, N. The influence of pre-planting mycorrhization of Scots pine seedlings on survival and growth of crops in forest fires. For. Agrofor. Improv. 2013, 123, 134–139. [Google Scholar]
- Mohan, V.; Nivea, R.; Menon, S. Evaluation of ectomycorrhizal fungi as potential bio-control agents against selected plant pathogenic fungi. JAIR 2015, 3, 408–412. [Google Scholar]
- Parladé, J.; Pera, J.; Alvarez, I.F. Inoculation of containerized Pseudotsuga menziesii and Pinus pinaster seedlings with spores of five species of ectomycorrhizal fungi. Mycorrhiza 1996, 6, 237–245. [Google Scholar] [CrossRef]
- Richter, D.L.; Bruhn, J.N. Scleroderma citrinum (Gasteromycetes, Sclerodermatales) and Larix decidua form ectomycorrhizae in pure culture. Nova Hedwig. 1990, 50, 355–360. [Google Scholar]
- Waller, K.; Raidl, S.; Agerer, R. Ectomycorrhizae of Scleroderma citrinum. Z. Mykol. 1993, 59, 141–153. [Google Scholar]
- Raidl, S. Studien zur Ontogenie an Rhizomorphen von Ektomykorrhizen; Cramer; Schweizerbart’sche Verlagsbuchhandlung: Berlin/Stuttgart, Germany, 1997; Volume 169. [Google Scholar]
- Voiry, H. Classification morphologique des ectomycorhizes du chêne et du hêtre dans le nord-est de la France. Eur. J. For. Pathol. 1981, 11, 284–299. [Google Scholar] [CrossRef]
- Godbout, C.; Fortin, J. Morphological features of synthesized ectomycorrhizae of Alnus crispa and A. rugosa. New Phytol. 1983, 94, 249–262. [Google Scholar] [CrossRef]
- Kumar, R.; Reddy, B.; Mohan, V. Distribution of ectomycorrhizal fungi in forest tree species of Andhra Pradesh, southern India—A new record. Indian For. 1999, 125, 496–502. [Google Scholar]
- Mrak, T.; Kühdorf, K.; Grebenc, T.; Štraus, I.; Münzenberger, B.; Kraigher, H. Scleroderma areolatum ectomycorrhiza on Fagus sylvatica L. Mycorrhiza 2017, 27, 283–293. [Google Scholar] [CrossRef]
- Alexopoulos, C.J.; Mims, C.W.; Blackwell, M. Introductory Mycology, 4th ed.; John Wiley and Sons: Hoboken, NJ, USA, 1996. [Google Scholar]
- Opoka, W.; Kała, K.; Krężałek, R.; Sułkowska-Ziaja, K.; Maślanka, A.; Muszyńska, B. TLC–densitometry analysis of indole compounds in mycelial culture of imleria badia and Agaricus bisporus enriched with precursors—serine or anthranilic acid. Acta Chromatogr. 2018, 30, 236–242. [Google Scholar] [CrossRef]
- Duñabeitia, M.K.; Hormilla, S.; Salcedo, I.; Peña, J.I. Ectomycorrhizae synthesized between Pinus radiata and eight fungi associated with Pinus spp. Mycologia 1996, 88, 897–908. [Google Scholar] [CrossRef]
- Taylor, M.K.; Lankau, R.A.; Wurzburger, N. Mycorrhizal associations of trees have different indirect effects on organic matter decomposition. J. Ecol. 2016, 104, 1576–1584. [Google Scholar] [CrossRef]
- Bennett, J.A.; Maherali, H.; Reinhart, K.O.; Lekberg, Y.; Hart, M.M.; Klironomos, J. Plant-soil feedbacks and mycorrhizal type influence temperate forest population dynamics. Science 2017, 355, 181–184. [Google Scholar] [CrossRef]
- Shah, F.; Nicolás, C.; Bentzer, J.; Ellström, M.; Smits, M.; Rineau, F.; Canbäck, B.; Floudas, D.; Carleer, R.; Lackner, G.; et al. Ectomycorrhizal fungi decompose soil organic matter using oxidative mechanisms adapted from saprotrophic ancestors. New Phytol. 2016, 209, 1705–1719. [Google Scholar] [CrossRef]
- Nicolás, C.; Martin-Bertelsen, T.; Floudas, D.; Bentzer, J.; Smits, M.; Johansson, T.; Troein, C.; Persson, P.; Tunlid, A. The soil organic matter decomposition mechanisms in ectomycorrhizal fungi are tuned for liberating soil organic nitrogen. ISME J. 2019, 13, 977–988. [Google Scholar] [CrossRef]
- Hatakeyama, T.; Ohmasa, M. Mycelial growth of strains of the genera Suillus and Boletinus in media with a wide range of concentrations of carbon and nitrogen sources. Mycoscience 2004, 45, 169–176. [Google Scholar] [CrossRef]
- Daza, A.; Manjon, J.; Camacho, M.; Romero De La Osa, L.; Aguilar, A.; Santamaria, C. Effect of carbon and nitrogen sources, pH and temperature on in vitro culture of several isolates of Amanita caesarea (Scop.: Fr.) Pers. Mycorrhiza 2006, 16, 133–136. [Google Scholar] [CrossRef]
- Voegele, R.T.; Struck, C.; Hahn, M.; Mendgen, K. The role of haustoria in sugar supply during infection of broad bean by the rust fungus Uromyces fabae. Proc. Natl. Acad. Sci. USA 2001, 98, 8133–8138. [Google Scholar] [CrossRef]
- Hughes, E.; Mitchell, D. Properties of invertases in mycelium of Hymenoscyphus ericae and in endomycorrhizal association with cranberry seedlings. Mycol. Res. 1996, 100, 1197–1203. [Google Scholar] [CrossRef]
- Calvaruso, C.; Turpault, M.P.; Leclerc, E.; Frey-Klett, P. Impact of ectomycorrhizosphere on the functional diversity of soil bacterial and fungal communities from a forest stand in relation to nutrient mobilization processes. Microb. Ecol. 2007, 54, 567–577. [Google Scholar] [CrossRef]
- Calvaruso, C.; Turpault, M.P.; Frey-Klett, P. Root-associated bacteria contribute to mineral weathering and to mineral nutrition in trees: A budgeting analysis. Appl. Environ. Microbiol. 2006, 72, 1258–1266. [Google Scholar] [CrossRef]
- Uroz, S.; Turpault, M.P.; Van Scholl, L.; Palin, B.; Frey-Klett, P. Long term impact of mineral amendment on the distribution of the mineral weathering associated bacterial communities from the beech Scleroderma citrinum ectomycorrhizosphere. Soil Biol. Biochem. 2011, 43, 2275–2282. [Google Scholar] [CrossRef]
- Zak, D.R.; Pellitier, P.T.; Argiroff, W.; Castillo, B.; James, T.Y.; Nave, L.E.; Averill, C.; Beidler, K.V.; Bhatnagar, J.; Blesh, J.; et al. Exploring the role of ectomycorrhizal fungi in soil carbon dynamics. New Phytol. 2019, 223, 33–39. [Google Scholar] [CrossRef] [PubMed]
- Bödeker, I.T.; Clemmensen, K.E.; de Boer, W.; Martin, F.; Olson, Å.; Lindahl, B.D. Ectomycorrhizal Cortinarius species participate in enzymatic oxidation of humus in northern forest ecosystems. New Phytol. 2014, 203, 245–256. [Google Scholar] [CrossRef] [PubMed]
- Craig, M.E.; Turner, B.L.; Liang, C.; Clay, K.; Johnson, D.J.; Phillips, R.P. Tree mycorrhizal type predicts within-site variability in the storage and distribution of soil organic matter. Glob. Chang. Biol. 2018, 24, 3317–3330. [Google Scholar] [CrossRef] [PubMed]
- Lindahl, B.D.; Ihrmark, K.; Boberg, J.; Trumbore, S.E.; Högberg, P.; Stenlid, J.; Finlay, R.D. Spatial separation of litter decomposition and mycorrhizal nitrogen uptake in a boreal forest. New Phytol. 2007, 173, 611–620. [Google Scholar] [CrossRef]
- Pringle, A.; Bever, J.D.; Gardes, M.; Parrent, J.L.; Rillig, M.C.; Klironomos, J.N. Mycorrhizal symbioses and plant invasions. Annu. Rev. Ecol. Evol. Syst. 2009, 40, 699–715. [Google Scholar] [CrossRef]
- Maltz, M.R.; Treseder, K.K. Sources of inocula influence mycorrhizal colonization of plants in restoration projects: A meta-analysis. Restor. Ecol. 2015, 23, 625–634. [Google Scholar] [CrossRef]
- Asmelash, F.; Bekele, T.; Birhane, E. The potential role of arbuscular mycorrhizal fungi in the restoration of degraded lands. Front. Microbiol. 2016, 7, 1095. [Google Scholar] [CrossRef] [PubMed]
- Roosens, N.; Verbruggen, N.; Meerts, P.; Ximenez-Embun, P.; Smith, J. Natural variation in cadmium tolerance and its relationship to metal hyperaccumulation for seven populations of Thlaspi caerulescens from western Europe. Plant Cell Environ. 2003, 26, 1657–1672. [Google Scholar] [CrossRef]
- Wu, J.; Qian, J.; Zheng, S. A preliminary study on ingredient of secretion from fungi of orchid mycorrhiza. J. Appl. Ecol. 2002, 13, 845–848. [Google Scholar]
- Kovalchuk, I.; Titov, V.; Hohn, B.; Kovalchuk, O. Transcriptome profiling reveals similarities and differences in plant responses to cadmium and lead. Mutat. Res. Mol. Mech. Mutagen. 2005, 570, 149–161. [Google Scholar] [CrossRef]
- Banerjee, S.; Flores-Rozas, H. Cadmium inhibits mismatch repair by blocking the ATPase activity of the MSH2–MSH6 complex. Nucleic Acids Res. 2005, 33, 1410–1419. [Google Scholar] [CrossRef]
- Di Toppi, L.S.; Lambardi, M.; Pecchion, N.; Pazzagli, L.; Durante, M.; Gabbrielli, R. Effects of cadmium stress on hairy roots of Daucus carota. J. Plant Physiol. 1999, 154, 385–391. [Google Scholar] [CrossRef]
- Di Toppi, L.S.; Gabbrielli, R. Response to cadmium in higher plants. Environ. Exp. Bot. 1999, 41, 105–130. [Google Scholar] [CrossRef]
- Kahle, H. Response of roots of trees to heavy metals. Environ. Exp. Bot. 1993, 33, 99–119. [Google Scholar] [CrossRef]
- Krupa, P.; Kozdrój, J. Ectomycorrhizal fungi and associated bacteria provide protection against heavy metals in inoculated pine (Pinus sylvestris L.) seedlings. Water Air Soil Pollut. 2007, 182, 83–90. [Google Scholar] [CrossRef]
- Wilkins, D. The influence of sheating (ecto-) mycorrhizas of trees on the uptake and toxicity of metals. Agric. Ecosyst. Environ. 1991, 35, 245–260. [Google Scholar] [CrossRef]
- Colpaert, J.V.; Van Laere, A.; van Assche, J.A. Carbon and nitrogen allocation in ectomycorrhizal and non-mycorrhizal Pinus sylvestris L. seedlings. Tree Physiol. 1996, 16, 787–793. [Google Scholar] [CrossRef] [PubMed]
- Adriaensen, K.; Vralstad, T.; Noben, J.P.; Vangronsveld, J.; Colpaert, J. Copper-adapted Suillus luteus, a symbiotic solution for pines colonizing Cu mine spoils. Appl. Environ. Microbiol. 2005, 71, 7279–7284. [Google Scholar] [CrossRef]
- Jentschke, G.; Godbold, D. Metal toxicity and ectomycorrhizas. Physiol. Plant. 2000, 109, 107–116. [Google Scholar] [CrossRef]
- Blaudez, D.; Jacob, C.; Turnau, K.; Colpaert, J.; Ahonen-Jonnarth, U.; Finlay, R.; Botton, B.; Chalot, M. Differential responses of ectomycorrhizal fungi to heavy metals in vitro. Mycol. Res. 2000, 104, 1366–1371. [Google Scholar] [CrossRef]
- Cejpková, J.; Gryndler, M.; Hršelová, H.; Kotrba, P.; Řanda, Z.; Synková, I.; Borovička, J. Bioaccumulation of heavy metals, metalloids, and chlorine in ectomycorrhizae from smelter-polluted area. Environ. Pollut. 2016, 218, 176–185. [Google Scholar] [CrossRef]
- Yan, W.; Jinming, G.; Shuanghong, H.; Xing, Z. Insecticidal activity of basidiomycete Scleroderma citrinum. Acta Bot.-Boreali-Occident. Sin. 2005, 25, 382–385. [Google Scholar]
- Ghate, S.; Sridhar, K.; Karun, N. Macrofungi on the coastal sand dunes of south-western India. Mycosphere 2014, 5, 144–151. [Google Scholar] [CrossRef]
- Soytong, K.; Sibounnavong, P.; Kanokmedhakul, K.; Kanokmedhakul, S. Biological active compounds of Scleroderma citrinum that inhibit plant pathogenic fungi. J. Agric. Technol. 2014, 10, 79–86. [Google Scholar]
- Kanokmedhakul, S.; Kanokmedhakul, K.; Prajuabsuk, T.; Soytong, K.; Kongsaeree, P.; Suksamrarn, A. A bioactive triterpenoid and vulpinic acid derivatives from the mushroom Scleroderma citrinum. Planta Medica 2003, 69, 568–571. [Google Scholar] [PubMed]
- Kasuya, M. Growth inhibition of pathogenic root fungi by extracts of ectomycorrhizal fungi or Picea glehnii inoculated with ectomycorrhizal fungi. BIOTROPIA-Southeast Asian J. Trop. Biol. 1996, 9, 53–61. [Google Scholar]
- Mbonyiryivuze, A.; Nuru, Z.; Ngom, B.D.; Mwakikunga, B.W.; Dhlamini, S.M.; Park, E.; Maaza, M. Morphological and chemical composition characterization of commercial sepia melanin. Am. J. Nanomater. 2015, 3, 22–27. [Google Scholar] [CrossRef]
- El-Naggar, N.E.A.; El-Ewasy, S.M. Bioproduction, characterization, anticancer and antioxidant activities of extracellular melanin pigment produced by newly isolated microbial cell factories Streptomyces glaucescens NEAE-H. Sci. Rep. 2017, 7, 42129. [Google Scholar] [CrossRef]
- Bresinsky, A.; Besl, H. A Colour Atlas of Poisonous Fungi; Wolfe Publishing: London, UK, 1991. [Google Scholar]
- Carrillo-González, R.; González-Chávez, M.d.C.A. Tolerance to and accumulation of cadmium by the mycelium of the fungi Scleroderma citrinum and Pisolithus tinctorius. Biol. Trace Elem. Res. 2012, 146, 388–395. [Google Scholar] [CrossRef]
- Muszynska, B.; Sulkowska-Ziaja, K.; Ekiert, H. Phenolic acids in selected edible basidiomycota species: Armillaria mellea, Boletus badius, Boletus edulis, Cantharellus cibarius, Lactarius deliciosus and Pleurotus ostreatus. Acta Sci. Pol. Hortorum Cultus 2013, 12, 107–116. [Google Scholar]
- Heleno, S.A.; Ferreira, R.C.; Antonio, A.L.; Queiroz, M.J.R.; Barros, L.; Ferreira, I.C. Nutritional value, bioactive compounds and antioxidant properties of three edible mushrooms from Poland. Food Biosci. 2015, 11, 48–55. [Google Scholar] [CrossRef]
- Fogarasi, M.; Socaciu, M.I.; Sălăgean, C.D.; Ranga, F.; Fărcaș, A.C.; Socaci, S.A.; Socaciu, C.; Țibulcă, D.; Fogarasi, S.; Semeniuc, C.A. Comparison of different extraction solvents for characterization of antioxidant potential and polyphenolic composition in Boletus edulis and Cantharellus cibarius mushrooms from Romania. Molecules 2021, 26, 7508. [Google Scholar] [CrossRef]
- Palmer, J. Techniques and Procedures for Culturing Ectomycorrhizal Fungi; USDA Miscellaneous Publications: Beltsville, Maryland, 1971.
- Espenshade, M. A study on the isolation and the cultivation of Basidiomycetes. In Developments in Industrial Microbiology, Proceedings of the 18th General Meeting of the Society for Industrial Microbiology, Lafayette, IN, USA, 27–31 August 1961; Purdue Univ., Ind.: West Lafayette, IN, USA, 1962; Volume 3, pp. 347–350. [Google Scholar]
- Oddoux, L. Essai de culture de 508 especes d’Homobasidiomycetes. Mushroom Sci. 1953, 2, 28–39. [Google Scholar]
- Minakov, D.; Morozhenko, Y.V.; Obrezkova, M.V.; Shavyrkina, N.A.; Egorova, E.Y. Study of deep cultivation of mushrooms of the genus Suillus for the purpose of obtaining protein food additives [Issledovaniye glubinnogo kul’tivirovaniya gribov roda maslenok (Suillus) c tsel’yu polucheniya belkovykh pishchevykh dobavok] (Russion). Polzunovsky Bull. 2020, 1, 32–36. [Google Scholar]
- Harley, J.L. The biology of Mycorrhiza, 2nd ed.; Leonard Hill: London, UK, 1969. [Google Scholar]
- Melin, E. Recent advances in the study of tree mycorrhiza. Trans. Br. Mycol. Soc. 1948, 30, 92–99. [Google Scholar] [CrossRef]
- Finlay, R.; Frostegård, Å.; Sonnerfeldt, A.M. Utilization of organic and inorganic nitrogen sources by ectomycorrhizal fungi in pure culture and in symbiosis with Pinus contorta Dougl. ex Loud. New Phytol. 1992, 120, 105–115. [Google Scholar] [CrossRef]
- Bukhalo, A.S. Higher Edible Basidiomycetes in Pure Culture; Institute of Botany, National Academy of Sciences of Ukraine: Kyiv, Ukraine, 1988. [Google Scholar]
- Friedmann, H.; Lubart, R.; Laulicht, I.; Rochkind, S. A possible explanation of laser-induced stimulation and damage of cell-cultures. J. Photochem. Photobiol. B-Biol. 1991, 11, 87–91. [Google Scholar] [CrossRef] [PubMed]
- Hilszczańska, D.; Oszako, T.; Sierota, Z. Influence of laser light on mycelial growth of Hebeloma mesophaeum and ectomycorrhizal development on Scots pine. Mycorrhiza 1999, 8, 323–327. [Google Scholar] [CrossRef]
- Ohta, A. A new medium for mycelial growth of mycorrhizal fungi. Trans. Mycol. Soc. Jpn. 1990, 31, 323–334. [Google Scholar]
- Nikitina, V.; Ozerova, R.; Tsivileva, O. Features of Lentinus edodes mycelium growth on various media [Osobennosti rosta mitseliya Lentinus edodes na razlichnykh sredakh] (Russian). Bull. Bot. Gard. Saratov State Univ. 2003, 2, 176–179. [Google Scholar]
- Kuznetsova, O. The influence of growth stimulants on the development of vegetative mycelium of Pleurotus ostreatus (Jacq: Fr.) Kumm [Vliyaniye stimulyatorov rosta na razvitiye vegetativnogo mitseliya Pleurotus ostreatus (Jacq: Fr.) Kumm] (Russion). Biotechnol. Acta 2011, 4, 082–089. [Google Scholar]
- Tan, Y.; Chang, S. Effect of growth regulators, enzyme inhibitors and stimulatory additives on the vegetative development and fructification of Lentinus edodes. In Mushroom Science XII (Part II), Proceedings of the Twelfth International Congress on the Science and Cultivation of Edible Fungi, Brauschweig, Germany, 20–26 September 1987; Institut für Bodenbiologie, Bundesforschungsanstalt für Landwirtschaft: Braunschweig, Germany, 1989; pp. 267–276. [Google Scholar]
- Laatikainen, T.; Heinonen-Tanski, H. Mycorrhizal growth in pure cultures in the presence of pesticides. Microbiol. Res. 2002, 157, 127–137. [Google Scholar] [CrossRef]
- Bukhalo, A.; Bisko, N.; Solomko, E. Cultivation of Edible and Medicinal Mushrooms; Practical Recommendations; Naukova Dumka: Kyiv, Ukraine, 2004. [Google Scholar]
- Kuznetsova, O.; Vlasenko, K. The influence of vegetable oils on the growth of mycelia of strains of the Pleurotus genus on agarized nutrient media and grain substrate [Vplyv roslynnykh oliy na rist mitseliyu shtamiv rodu Pleurotus na aharyzovanykh zhyvylnykh seredovyshchakh ta zernovomu substrati] (Ukrainian). In Proceedings of the XVI All-Ukrainian Scientific and Practical Conference of Students, Postgraduates and Young Scientists "Biotechnology of the XXI Century", Kyiv, Ukraine, 22–23 September 2009; Volume 25, p. 64. [Google Scholar]
- Kelly, A.K. Plant Mycotrophy [Mikotrofiya Rasteniy] (Russion); Foreign Literature Publishing House: Moscow, Russia, 1952. [Google Scholar]
- Barea, J.; Olivares, J. Manejo de las propiedades biológicas del suelo. In Agricultura Sostenible; Diaz, J.R., de Espinosa, L.R., Eds.; Editorial Mundi Prensa: Madrid, Spain, 1998; pp. 173–193. [Google Scholar]
- Schloter, M.; Nannipieri, P.; Sørensen, S.J.; van Elsas, J.D. Microbial indicators for soil quality. Biol. Fertil. Soils 2018, 54, 1–10. [Google Scholar] [CrossRef]
- Agerer, R. Characterization of ectomycorrhizae: A historical overview. Descript Ectomycorrhizae 1996, 1, 1–22. [Google Scholar]
- Pereira, O.L.; Kasuya, M.C.M.; Borges, A.C.; Araújo, E.F.d. Morphological and molecular characterization of mycorrhizal fungi isolated from neotropical orchids in Brazil. Can. J. Bot. 2005, 83, 54–65. [Google Scholar] [CrossRef]
- Tsavkelova, E.; Klimova, S.; Chsrdyntseva, T.; Nstrusov, L. Microorganisms producing plant growth stimulants and their practical application (review) [Mikroorganizmy-produtsenty stimulyatorov rosta rasteniy i ikh prakticheskoye primeneniye (obzor) (Russian)]. Appl. Biochem. Microbiol. 2006, 42, 133–143. [Google Scholar]
- Göbl, F.; Platzer, H. Düngung und Mykorrhizabildung bei Zirbenjungpflanzen; Österr. Agrarverl. [i. Komm.]: Wien, Austria, 1967. [Google Scholar]
- Rygiewicz, P.T.; Andersen, C.P. Mycorrhizae alter quality and quantity of carbon allocated below ground. Nature 1994, 369, 58–60. [Google Scholar] [CrossRef]
- Attiwill, P.M.; Adams, M.A. Nutrient cycling in forests. New Phytol. 1993, 124, 561–582. [Google Scholar] [CrossRef]
- Machón, P.; Pajares, J.; Diez, J.; Alves-Santos, F. Influence of the ectomycorrhizal fungus Laccaria laccata on pre-emergence, post-emergence and late damping-off by Fusarium oxysporum and F. verticillioides on Stone pine seedlings. Symbiosis 2009, 49, 101–109. [Google Scholar] [CrossRef]
- Syrenko, O.G.; Belova, N.; Maltsov, I.Y.; Marynyuk, M.M.; Sokol, V. Mycorrhiza of Pinus selvestris L. and Picea abies (L.) Karst. in natural and cultural conditions and the results of artificial mycorrhization of seedlings [Mikoryza Pinus selvestris L. and Picea abies (L.) Karst. v pryrodnykh umovakh ta umovakh kul’tury ta rezul’taty shtuchnoyi mikoryzatsiyi sadzhantsiv] (Ukrainian). Precarpathian Natl. Univ. Repos. Period. Pnu Visnyki Ser. Biol. 2011, 15, 224–234. [Google Scholar]
- Salgado Salomón, M.E.; Barroetaveña, C.; Rajchenberg, M. Do pine plantations provide mycorrhizal inocula for seedlings establishment in grasslands from Patagonia, Argentina? New For. 2011, 41, 191–205. [Google Scholar] [CrossRef]
- Aleksandrowicz-Trzcinska, M.; Buraczyk, W. The growth and mycorrhizal status of Scots pine seedlings planted on a outer dumping ground of the Lignite Mine in Belchatow using different methods of seedling production. Folia For. Pol. Ser. A For. 2008, 49. [Google Scholar] [CrossRef]
- Buraczyk, W.; Szeligowski, H.; Aleksandrowicz-Trzcińska, M.; Drozdowski, S.; Jakubowski, P. Wzrost mikoryzowanych i niemikoryzowanych sadzonek sosny zwyczajnej (Pinus sylvestris L.) w warunkach zróżnicowanej wilgotności i żyzności podłoża. Sylwan 2012, 156, 100–111. [Google Scholar]
- Andreeva, E.; Stetsenko, S.; Hurshkainen, T.; Terekhov, G.; Kutchin, A. The mycorrhization of the root system of Scots pine with different granulometric composition of the soil under the influence of bio-stimulants in the Middle Urals. In Proceedings of the AIP Conference Proceedings, Ekaterinburg, Russia, 18–21 November 2020; AIP Publishing: Ekaterinburg, Russia, 2022; Volume 2390. [Google Scholar]
- Hilszczanska, D. Stan symbiozy mikoryzowej i wzrost inokulowanych siewek sosny Pinus sylvestris L. rosnacych w szklarni w warunkach roznej wilgotnosci podloza. Sylwan 2001, 145, 89–95. [Google Scholar]
- Hilszczanska, D. Wplyw deszczowania na kolonizacje mikoryzowa i zawartosc ergosterolu w korzeniach siewek sosny zwyczajnej [Pinus sylvestris L.]. Pr. Inst. Badaw. Leśnictwa Ser. A 2003, 4, 55–64. [Google Scholar]
- Hilszczanska, D. Mycorrhizal status of Scots pine Pinus sylvestris L. seedlings grown in watered and non-watered nursery condition. Dendrobiology 2004, 52, 23–28. [Google Scholar]
- Hilszczanska, D. Wplyw deszczowania siewek Pinus sylvestris L. na zmiany w zbiorowiskach grzybow mikoryzowych i glebowych. Leśne Pr. Badaw. 2005, 4, 103–113. [Google Scholar]
- Hoeksema, J.D.; Averill, C.; Bhatnagar, J.M.; Brzostek, E.; Buscardo, E.; Chen, K.H.; Liao, H.L.; Nagy, L.; Policelli, N.; Ridgeway, J.; et al. Ectomycorrhizal plant-fungal co-invasions as natural experiments for connecting plant and fungal traits to their ecosystem consequences. Front. For. Glob. Chang. 2020, 3, 84. [Google Scholar] [CrossRef]
- Compant, S.; Van Der Heijden, M.G.; Sessitsch, A. Climate change effects on beneficial plant–microorganism interactions. Fems Microbiol. Ecol. 2010, 73, 197–214. [Google Scholar] [CrossRef] [PubMed]
- Classen, A.T.; Sundqvist, M.K.; Henning, J.A.; Newman, G.S.; Moore, J.A.; Cregger, M.A.; Moorhead, L.C.; Patterson, C.M. Direct and indirect effects of climate change on soil microbial and soil microbial-plant interactions: What lies ahead? Ecosphere 2015, 6, 1–21. [Google Scholar] [CrossRef]
- Bellgard, S.E.; Williams, S.E. Response of mycorrhizal diversity to current climatic changes. Diversity 2011, 3, 8–90. [Google Scholar] [CrossRef]
- Milović, M.; Kebert, M.; Orlović, S. How mycorrhizas can help forests to cope with ongoing climate change? Šumarski List 2021, 145, 279–286. [Google Scholar] [CrossRef]
- Hawkins, H.J.; Cargill, R.I.; Van Nuland, M.E.; Hagen, S.C.; Field, K.J.; Sheldrake, M.; Soudzilovskaia, N.A.; Kiers, E.T. Mycorrhizal mycelium as a global carbon pool. Curr. Biol. 2023, 33, R560–R573. [Google Scholar] [CrossRef]
- Bennett, A.E.; Classen, A.T. Climate change influences mycorrhizal fungal–plant interactions, but conclusions are limited by geographical study bias. Ecology 2020, 101, e02978. [Google Scholar] [CrossRef]
- Duarte, A.G.; Maherali, H. A meta-analysis of the effects of climate change on the mutualism between plants and arbuscular mycorrhizal fungi. Ecol. Evol. 2022, 12, e8518. [Google Scholar] [CrossRef]
- Diez, J.M.; James, T.Y.; McMunn, M.; Ibáñez, I. Predicting species-specific responses of fungi to climatic variation using historical records. Glob. Change Biol. 2013, 19, 3145–3154. [Google Scholar] [CrossRef]
- Xiao, D.; Chen, Y.; He, X.; Xu, Z.; Bai, S.H.; Zhang, W.; Cheng, M.; Hu, P.; Wang, K. Temperature and precipitation significantly influence the interactions between arbuscular mycorrhizal fungi and diazotrophs in karst ecosystems. For. Ecol. Manag. 2021, 497, 119464. [Google Scholar] [CrossRef]
- Bainard, L.D.; Dai, M.; Gomez, E.F.; Torres-Arias, Y.; Bainard, J.D.; Sheng, M.; Eilers, W.; Hamel, C. Arbuscular mycorrhizal fungal communities are influenced by agricultural land use and not soil type among the Chernozem great groups of the Canadian Prairies. Plant Soil 2015, 387, 351–362. [Google Scholar] [CrossRef]
- Carrenho, R.; Trufem, S.F.B.; Bononi, V.L.R.; Silva, E.S. The effect of different soil properties on arbuscular mycorrhizal colonization of peanuts, sorghum and maize. Acta Bot. Bras. 2007, 21, 723–730. [Google Scholar] [CrossRef]
- Jerbi, M.; Labidi, S.; Bahri, B.A.; Laruelle, F.; Tisserant, B.; Jeddi, F.B.; Sahraoui, A.L.H. Soil properties and climate affect arbuscular mycorrhizal fungi and soil microbial communities in Mediterranean rainfed cereal cropping systems. Pedobiologia 2021, 87, 150748. [Google Scholar] [CrossRef]
- Usman, M.; Ho-Plágaro, T.; Frank, H.E.; Calvo-Polanco, M.; Gaillard, I.; Garcia, K.; Zimmermann, S.D. Mycorrhizal symbiosis for better adaptation of trees to abiotic stress caused by climate change in temperate and boreal forests. Front. For. Glob. Chang. 2021, 4, 141. [Google Scholar] [CrossRef]
- Boutasknit, A.; Baslam, M.; Ait-El-Mokhtar, M.; Anli, M.; Ben-Laouane, R.; Ait-Rahou, Y.; Mitsui, T.; Douira, A.; El Modafar, C.; Wahbi, S.; et al. Assemblage of indigenous arbuscular mycorrhizal fungi and green waste compost enhance drought stress tolerance in carob (Ceratonia siliqua L.) trees. Sci. Rep. 2021, 11, 22835. [Google Scholar] [CrossRef] [PubMed]
- Lenoir, I.; Fontaine, J.; Sahraoui, A.L.H. Arbuscular mycorrhizal fungal responses to abiotic stresses: A review. Phytochemistry 2016, 123, 4–15. [Google Scholar] [CrossRef] [PubMed]
- Jadrane, I.; Dounas, H.; Kouisni, L.; Aziz, F.; Ouahmane, L. Inoculation with selected indigenous mycorrhizal complex improves Ceratonia siliqua’s growth and response to drought stress. Saudi J. Biol. Sci. 2021, 28, 825–832. [Google Scholar] [CrossRef]
- Habeeb, T.H.; Abdel-Mawgoud, M.; Yehia, R.S.; Khalil, A.M.A.; Saleh, A.M.; AbdElgawad, H. Interactive impact of arbuscular mycorrhizal fungi and elevated CO2 on growth and functional food value of Thymus vulgare. J. Fungi 2020, 6, 168. [Google Scholar] [CrossRef]
- Zhu, X.; Song, F.; Liu, S.; Liu, F. Role of arbuscular mycorrhiza in alleviating salinity stress in wheat (Triticum aestivum L.) grown under ambient and elevated CO2. J. Agron. Crop Sci. 2016, 202, 486–496. [Google Scholar] [CrossRef]
- Chávez, D.; Rivas, G.; Machuca, Á.; Santos, C.; Deramond, C.; Aroca, R.; Cornejo, P. Contribution of Arbuscular Mycorrhizal and Endophytic Fungi to Drought Tolerance in Araucaria araucana Seedlings. Plants 2023, 12, 2116. [Google Scholar] [CrossRef]
- Sebastiana, M.; da Silva, A.B.; Matos, A.R.; Alcântara, A.; Silvestre, S.; Malhó, R. Ectomycorrhizal inoculation with Pisolithus tinctorius reduces stress induced by drought in cork oak. Mycorrhiza 2018, 28, 247–258. [Google Scholar] [CrossRef]
- Begum, N.; Qin, C.; Ahanger, M.A.; Raza, S.; Khan, M.I.; Ashraf, M.; Ahmed, N.; Zhang, L. Role of arbuscular mycorrhizal fungi in plant growth regulation: Implications in abiotic stress tolerance. Front. Plant Sci. 2019, 10, 1068. [Google Scholar] [CrossRef]
- Cosme, M. Mycorrhizas drive the evolution of plant adaptation to drought. Commun. Biol. 2023, 6, 346. [Google Scholar] [CrossRef]
- Labouyrie, M.; Ballabio, C.; Romero, F.; Panagos, P.; Jones, A.; Schmid, M.W.; Mikryukov, V.; Dulya, O.; Tedersoo, L.; Bahram, M.; et al. Patterns in soil microbial diversity across Europe. Nat. Commun. 2023, 14, 3311. [Google Scholar] [CrossRef]
- Afkhami, M.E. Past microbial stress benefits tree resilience. Science 2023, 380, 798–799. [Google Scholar] [CrossRef]
- Zak, B. Role of mycorrhizae in root disease. Annu. Rev. Phytopathol. 1964, 2, 377–392. [Google Scholar] [CrossRef]
- Hatch, A. The role of mycorrhizae in afforestation. J. For. 1936, 34, 22–29. [Google Scholar]
- Garrett, S.D. Biology of Root-Infecting Fungi. Soil Sci. 1956, 82, 97. [Google Scholar] [CrossRef]
- Katznelson, H.; Lochhead, A.; Timonin, M. Soil microorganisms and the rhizosphere. Bot. Rev. 1948, 14, 543–586. [Google Scholar] [CrossRef]
- Neal, J., Jr.; Bollen, W.; Zak, B. Rhizosphere microflora associated with mycorrhizae of Douglas fir. Can. J. Microbiol. 1964, 10, 259–265. [Google Scholar] [CrossRef]
- Azcón-Aguilar, C.; Jaizme-Vega, M.; Calvet, C. The contribution of arbuscular mycorrhizal fungi to the control of soil-borne plant pathogens. In Mycorrhizal Technology in Agriculture: From Genes to Bioproducts; Springer: Berlin/Heidelberg, Germany, 2002; pp. 187–197. [Google Scholar]
- Tripathi, S.; Mishra, S.K.; Varma, A. Mycorrhizal fungi as control agents against plant pathogens. Mycorrhiza-Nutrient Uptake, Biocontrol, Ecorestoration; Birkhäuser: Basel, Switzerland, 2017; pp. 161–178. [Google Scholar]
- Zhdanyuk, I. The Effect of Mycorrhizal Preparation on the Productivity of Soybeans under Polissia Conditions; Technical Report; Institutional Repository of Polissia National University: Zhytomyr, Ukraine, 2020. (In Ukrainian) [Google Scholar]
- Hatch, A.; Doak, K. Mycorrhizal and other features of the root systems of Pinus. J. Arnold Arbor. 1933, 14, 85–99. [Google Scholar] [CrossRef]
- Chakravarty, P.; Unestam, T. Differential influence of ectomycorrhizae on plant growth and disease resistance in Pinus sylvestris seedlings. J. Phytopathol. 1987, 120, 104–120. [Google Scholar] [CrossRef]
- Melin, E. Über die Mykorrhizenpilze von Pinus silvestris L. und Picea abies (L.) Karst: Vorläufige Mitteilung. Sven. Bot. Tidskr. 1921, 15, 192–203. [Google Scholar]
- Rayner, M.; Levisohn, I. The mycorrhizal habit in relation to forestry: IV. Studies on mycorrhizal response in Pinus and other conifers. For. Int. J. For. Res. 1941, 15, 1–36. [Google Scholar] [CrossRef]
- Doak, K.D.; Fisher, P.L. Mycorrhizal and pseudomycorrhizal infections of pine roots during first year’s growth (Abstr.). Phytopathology 1935, 25, 14. [Google Scholar]
- Radić, N.; Štrukelj, B. Endophytic fungi—The treasure chest of antibacterial substances. Phytomedicine 2012, 19, 1270–1284. [Google Scholar] [CrossRef]
- Neethu, S.; Midhun, S.J.; Radhakrishnan, E.; Jyothis, M. Green synthesized silver nanoparticles by marine endophytic fungus Penicillium polonicum and its antibacterial efficacy against biofilm forming, multidrug-resistant Acinetobacter baumanii. Microb. Pathog. 2018, 116, 263–272. [Google Scholar] [CrossRef]
- Brown, H.J. Publications of the Southeastern Forest Experiment Station, 1959–1963; U.S. Department of Agriculture, Forest Service, Southeastern Forest Experiment Station: Asheville, NC, USA, 1965.
- Brown, R.T.; Mikola, P. The Influence of Fruticose Soil Lichens upon the Mycorrhizae and Seedling Growth of Forest Trees; Suomen Metsätieteellinen Seura: Helsinki, Finland, 1974. [Google Scholar]
- Santoro, T.; Casida, L., Jr. Elaboration of antibiotics by Boletus luteus and certain other mycorrhizal fungi. Can. J. Microbiol. 1962, 8, 43–48. [Google Scholar] [CrossRef]
- Hyppel, A. Antagonistic effects of some soil fungi on Fomes annosus in laboratory experiments. Stud. For. Suec. 1968, 64, 1–18. [Google Scholar]
- Wilcox, H.; Wang, C. Ectomycorrhizal and ectendomycorrhizal associations of Phialophora finlandia with Pinus resinosa, Picea rubens, and Betula alleghaniensis. Can. J. For. Res. 1987, 17, 976–990. [Google Scholar] [CrossRef]
- Lofgren, L.; Nguyen, N.H.; Kennedy, P.G. Ectomycorrhizal host specificity in a changing world: Can legacy effects explain anomalous current associations? New Phytol. 2018, 220, 1273–1284. [Google Scholar] [CrossRef]
- Taniguchi, T.; Kataoka, R.; Futai, K. Plant growth and nutrition in pine (Pinus thunbergii) seedlings and dehydrogenase and phosphatase activity of ectomycorrhizal root tips inoculated with seven individual ectomycorrhizal fungal species at high and low nitrogen conditions. Soil Biol. Biochem. 2008, 40, 1235–1243. [Google Scholar] [CrossRef]
- Pozo de la Hoz, J.; Rivero, J.; Azcón-Aguilar, C.; Urrestarazu, M.; Pozo, M.J. Mycorrhiza-induced resistance against foliar pathogens is uncoupled of nutritional effects under different light intensities. J. Fungi 2021, 7, 402. [Google Scholar] [CrossRef] [PubMed]

Disclaimer/Publisher’s Note: The statements, opinions and data contained in all publications are solely those of the individual author(s) and contributor(s) and not of MDPI and/or the editor(s). MDPI and/or the editor(s) disclaim responsibility for any injury to people or property resulting from any ideas, methods, instructions or products referred to in the content. |
© 2024 by the authors. Licensee MDPI, Basel, Switzerland. This article is an open access article distributed under the terms and conditions of the Creative Commons Attribution (CC BY) license (https://creativecommons.org/licenses/by/4.0/).
Share and Cite
Dyshko, V.; Hilszczańska, D.; Davydenko, K.; Matić, S.; Moser, W.K.; Borowik, P.; Oszako, T. An Overview of Mycorrhiza in Pines: Research, Species, and Applications. Plants 2024, 13, 506. https://doi.org/10.3390/plants13040506
Dyshko V, Hilszczańska D, Davydenko K, Matić S, Moser WK, Borowik P, Oszako T. An Overview of Mycorrhiza in Pines: Research, Species, and Applications. Plants. 2024; 13(4):506. https://doi.org/10.3390/plants13040506
Chicago/Turabian StyleDyshko, Valentyna, Dorota Hilszczańska, Kateryna Davydenko, Slavica Matić, W. Keith Moser, Piotr Borowik, and Tomasz Oszako. 2024. "An Overview of Mycorrhiza in Pines: Research, Species, and Applications" Plants 13, no. 4: 506. https://doi.org/10.3390/plants13040506
APA StyleDyshko, V., Hilszczańska, D., Davydenko, K., Matić, S., Moser, W. K., Borowik, P., & Oszako, T. (2024). An Overview of Mycorrhiza in Pines: Research, Species, and Applications. Plants, 13(4), 506. https://doi.org/10.3390/plants13040506

